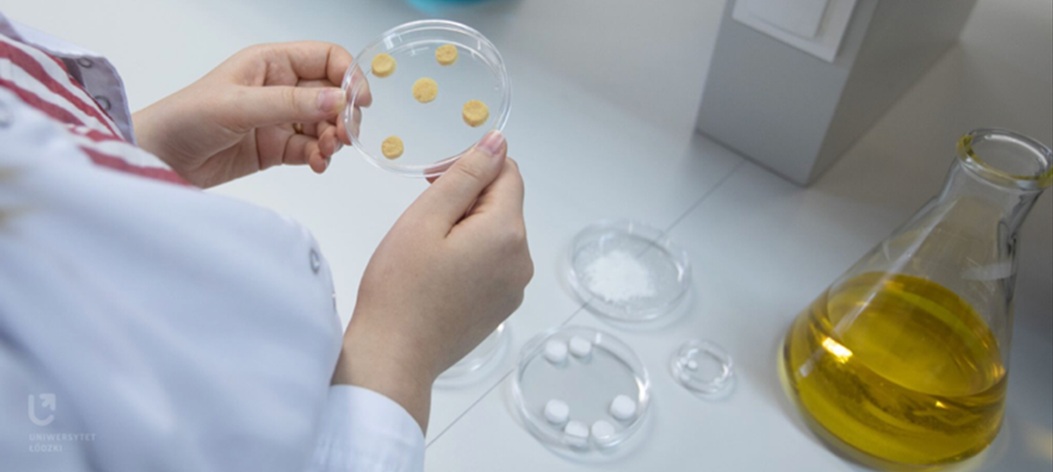

- Uniwersytet Łódzki
- Współpraca
- Centrum Transferu Technologii
- Dla Biznesu
- Oferta Technologiczna
Oferta Technologiczna
Poznaj technologie opracowane przez naukowców Uniwersytetu Łódzkiego.
Poznaj nasze technologie

Czujnik kardiologiczny do badania lewokomorowej niewydolności serca
Poziom TRL: 6*Słowa kluczowe: niewydolność serca, płyn przesiękowy, promieniowanie mikrofalowe, przenikalność dielektryczna

Sposób otrzymywania magnetycznego, hybrydowego kompozytu polimerowego.
Status IP: zgłoszenie patentowe nr P.439879 z dnia 17.12.2021Poziom TRL: 4*Słowa kluczowe: kompozyt polimerowy, włókno konopne (celulozowe), pentakarbonylek żelaza

Kompaktowy Obiekt Retencyjno-Doczyszczający (KORD)
Status IP: zgłoszenie patentowe w trakcie przygotowywaniaPoziom TRL: 7*Słowa kluczowe: ekohydrologia, poprawa ilości i jakości wody, bioróżnorodność, usługi ekosystemowe

Test do wykrywania jonów rtęci
Status IP: zgłoszenie w trakcie opracowywaniaPoziom TRL: 6*Słowa kluczowe: czujniki luminescencyjne, sensory środowiska, jony rtęci, detekcja

ToxoCure
Poziom TRL: 7*Słowa kluczowe: toksoplazmoza, wczesna diagnoza

UP!app – innowacyjna forma wsparcia i rozwoju pracowników na odległość.
Poziom TRL: 6*Status IP: know howSłowa kluczowe: kapitał psychologiczny pracowników, doświadczenie pracownika, wsparcie pracowników, budowanie dobrostan psychologicznego

Elektrochemiczne sensory do oznaczania heroiny
Status IP: P.440575 [WIPO ST 10/C PL440575] Poziom TRL: 6* Słowa kluczowe: heroina, proszki uliczne, sensor, elektroanaliza, elektrochemia, miniaturyzacja

Preparat anty-opryszczkowy na bazie nanocząstek metalicznych i związków pochodzenia naturalnego
Status IP: patent nr PL 234349 Poziom TRL: 4* Słowa kluczowe: preparat antywirusowy, leczenie opryszczki, łagodzenie skutków opryszczki, wirus HSV, nanocząstki metali, polifenole
Biokompozyty do odbudowy ubytków kostnych
Status IP: P.443751 i P.443750 oraz PCT WO 2024/167424/PL2023/050048, know-howPoziom TRL: 4* (wykonano działający prototyp laboratoryjny)Słowa kluczowe: biomateriał, kompozyt kostny, implant,…

AMP OLED
Poziom TRL: 5*Słowa kluczowe: luminescencja, organiczne diody elektroluminescencyjne, OLED
Opracowanie i komercjalizacja biopreparatu do stymulacji naturalnych procesów biodegradacji herbicydów w glebie
Poziom TRL: 5*Słowa kluczowe: herbicydy fenoksykwasowe, biopreparat, biodegredacja, bioremediacja, wtórne metabolity roślinne

Sposób oznaczania chininy
Status IP: P.436383 [WIPO ST 10/C PL436383] Poziom TRL: 6*Słowa kluczowe: chinina, sensor, elektrochemia, przejście jonowe, miniaturyzacja